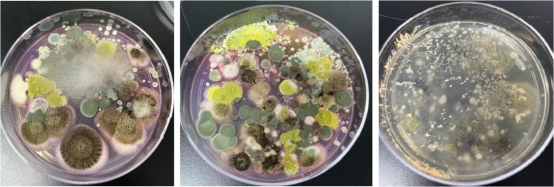

隨著體外診斷技術(shù)的不斷創(chuàng)新,我國(guó)體外診斷試劑行業(yè)獲得快速發(fā)展,相關(guān)產(chǎn)品更是日新月異,不斷升級(jí)。在配制各種液體試劑或液體制劑中。特別是體外診斷試劑的研發(fā)、生產(chǎn)過程中,除準(zhǔn)確性和重復(fù)性外,同樣需保證產(chǎn)品的良好適用性和品質(zhì),且低毒高效、通用性廣、生態(tài)環(huán)境友好。
在體外診斷試劑行業(yè)中,殺菌抑菌等防腐劑的選擇至關(guān)重要,決定體外診斷試劑質(zhì)量的好壞。西寶生物十多年作為生物試劑原料專業(yè)服務(wù)商,一直致力于提供長(zhǎng)效、廣譜、高效、低毒、環(huán)保的防腐劑。自主開發(fā)的新型無毒環(huán)保體外診斷試劑專用防腐劑KroVin500 (KV500),可替代傳統(tǒng)的NaN3、硫柳汞等對(duì)人體及環(huán)境毒害大的防腐劑產(chǎn)品。詳情咨詢400-021-8158或訪問我司網(wǎng)站www.0571x.cn.
KroVin 500防腐劑(活性成份為α-巰基-N-氧化物水溶液)
作用機(jī)理
KroVin500生物防腐劑作為離子載體,可穿過細(xì)菌的細(xì)胞膜,將質(zhì)子運(yùn)入細(xì)胞,攜帶鉀離子離去,經(jīng)過反復(fù)穿梭破壞了細(xì)胞膜兩邊的離子梯度,使細(xì)胞膜不能運(yùn)輸養(yǎng)分而導(dǎo)致細(xì)胞死亡。
在此過程中,KroVin500自身并沒有消耗,故能持續(xù)發(fā)揮作用。
產(chǎn)品特點(diǎn)
- 防霉抗菌效果極佳:本品對(duì)黑曲霉、黃曲霉、變色曲霉、桔青霉、宛氏擬青霉、綠色木霉、球毛殼霉、臘葉芽枝霉等顯示出極佳霉菌防霉抗菌效果。
- 細(xì)菌抗菌效果優(yōu)秀:本品對(duì)大腸桿菌、金黃色葡萄球菌、桔草芽胞桿菌、巨大芽孢桿菌、熒光假單胞桿菌等細(xì)菌均顯示出優(yōu)秀的抑殺效果。
- 酵母抗菌效果良好:本品對(duì)酒精酵母、啤酒酵母等多種酵母菌均顯示出良好的抑殺效果。
- 安全性高:對(duì)小鼠急性經(jīng)口LD50>1000mg/kg;對(duì)皮膚無刺激性;三致試驗(yàn)陰性。
- 溶劑相溶性:易溶于水,在pH5-11范圍內(nèi)都有效;特別適合在堿性和中性條件下穩(wěn)定,酸性條件下效果略有下降。
- 廣譜、長(zhǎng)效,替代傳統(tǒng)的防腐劑:NaN3、硫柳汞等對(duì)人體及環(huán)境毒害大的產(chǎn)品。
- 它與重金屬離子能發(fā)生螯合反應(yīng)(可中和重金屬離子對(duì)產(chǎn)品或配液體系干擾)。
質(zhì)量指標(biāo):
Active principle | 40.0%~41.0% |
Density | 1.10~1.3 g/ml |
pH | 9.0~11.0 |
Shape and properties | Light yellow liquid |
應(yīng)用領(lǐng)域
KroVin 500系列防腐劑pH耐受適用范圍廣,pH 5~11(最適PH6.5~10.5),化學(xué)穩(wěn)定性好,可與水及陰離子、陽離子、非離子等各種離子型乳化劑、表面活性劑以及血清、蛋白質(zhì)、酶等配伍。
適用比例:0.05~0.2%;具體根據(jù)樣本體系確定,必要時(shí)可提高濃度。也可與KroVin300、KroVin360混合使用,效果更好。
主要有以下應(yīng)用:
1)對(duì)照品、包被液、封閉液、穩(wěn)定液、稀釋液、緩沖液;
2)血?dú)夥治?、血球試劑、稀釋液等?
3)校準(zhǔn)液(pH等);
4)清洗液和容器、管道、水槽等清洗和消殺抑菌;
5)體外診斷試劑盒和試劑配制。
6) 也可配制消毒劑、洗潔劑和廣譜抗真菌皮膚科用藥等產(chǎn)品。
1)對(duì)照品、包被液、封閉液、穩(wěn)定液、稀釋液、緩沖液;
2)血?dú)夥治?、血球試劑、稀釋液等?
3)校準(zhǔn)液(pH等);
4)清洗液和容器、管道、水槽等清洗和消殺抑菌;
5)體外診斷試劑盒和試劑配制。
6) 也可配制消毒劑、洗潔劑和廣譜抗真菌皮膚科用藥等產(chǎn)品。
包裝儲(chǔ)存
本品包裝規(guī)格為25ml、100ml、500ml、5L。在正常室溫儲(chǔ)存情況下,可穩(wěn)定儲(chǔ)存二年。儲(chǔ)存期內(nèi),如發(fā)現(xiàn)沉淀物,使用前混合均勻,不影響其殺菌效果。
注意事項(xiàng)
1、本品雖然低毒、使用安全,但仍需避免接觸嘴巴、眼睛和皮膚。操作時(shí)請(qǐng)做好防護(hù)工作。
2、請(qǐng)于避光陰涼處貯存。
3、本品與一些氧化劑不相容,如過酸鹽、亞硫酸鹽等。對(duì)光、氧化劑和強(qiáng)還原劑不穩(wěn)定。非離子表面活性劑會(huì)微弱影響(可適當(dāng)加大用量),它與重金屬離子能發(fā)生螯合反應(yīng)(可中和重金屬離子對(duì)產(chǎn)品或配液體系干擾)。
4、使用時(shí)溫度不要超過45℃。
Seebio更多防腐劑系列應(yīng)用領(lǐng)域
應(yīng)用 產(chǎn)品系列 | PH適用范圍 | 免疫層析、膠體金 | 酶聯(lián)免疫、化學(xué)發(fā)光 | 生化 | 血?dú)夥治?血球 | 儀器設(shè)備管道清洗消毒 | ||
對(duì)照品 | 樣本 稀釋液 | 酶標(biāo) 稀釋液 | ||||||
KroVin 100 | ☆ | ☆ | ||||||
KroVin 200 | 3-9.5 | ☆ | ☆ | ☆ | ☆ | ☆ | ||
KroVin 300 | 2-9.5 | ☆ | ☆ | ☆ | ☆ | ☆ | ||
KroVin 360 | 3-8.5 | ☆ | ☆ | ☆ | ☆ | ☆ | ☆ | ☆ |
KroVin 500 | 5-11 | ☆ | ☆ | ☆ | ☆ | |||
KroVin 950 | 2-12 | ☆ | ☆ | ☆ | ☆ | ☆ | ||
KroVin 500殺抑菌效果測(cè)試與性能比較
一、實(shí)驗(yàn)原理
通過KroVin 500等系列工作濃度、接種到易染實(shí)驗(yàn)室及倉庫等環(huán)境試驗(yàn)菌的培養(yǎng)皿,在一定時(shí)間培養(yǎng)過程中,隨著各抑菌劑從原點(diǎn)向周圍的輻射,會(huì)有圓形區(qū)域無法長(zhǎng)出菌苔,從而顯示其抑菌作用。實(shí)驗(yàn)通過抑菌圈及直徑大小判斷其抑菌能力。
二、實(shí)驗(yàn)用品
85mm 培養(yǎng)皿、離心管、移液器、移液管、生物安全柜、生理鹽水、恒溫培養(yǎng)箱、無菌純水、接種環(huán)、涂棒、孟加拉紅瓊脂培養(yǎng)基、大豆胰蛋白培養(yǎng)基等。
三、菌種
取西寶公司實(shí)驗(yàn)室、生產(chǎn)車間、倉庫、過道的角落和設(shè)備處,用無菌棉球蘸取污物,接種到營(yíng)養(yǎng)肉湯瓊脂平板、孟加拉紅瓊脂平板、馬鈴薯葡萄糖瓊脂平板,32℃培養(yǎng)長(zhǎng)出菌落菌苔,挑取平板上易感代表性的菌落加入生理鹽水,制成混合菌接種液,接種液麥?zhǔn)蠞岫? 左右。
四、抑制劑
KroVin300(下圖簡(jiǎn)稱“KV300”,貨號(hào):ACN0037B,品牌:Seebio)
KroVin360(下圖簡(jiǎn)稱“KV360”,貨號(hào):ACN0917A,品牌:Seebio)
KroVin500(下圖簡(jiǎn)稱“KV500”,貨號(hào):ACN0046A,品牌:Seebio)
Proclin 300(下圖簡(jiǎn)稱“P*300”,品牌:進(jìn)口某Si*a品牌)
KroVin360(下圖簡(jiǎn)稱“KV360”,貨號(hào):ACN0917A,品牌:Seebio)
KroVin500(下圖簡(jiǎn)稱“KV500”,貨號(hào):ACN0046A,品牌:Seebio)
Proclin 300(下圖簡(jiǎn)稱“P*300”,品牌:進(jìn)口某Si*a品牌)
五、操作
1、將4 種抑制劑配制成1:250、1:500、1:1000、1:2000 的樣品存放2-8 度待用。配制大豆絡(luò)蛋白和孟加拉紅瓊脂培養(yǎng)基,各200ml,121℃滅菌15min,潔凈
2、生物安全柜內(nèi)冷卻至50℃左右,各加入3ml 接種液,搖晃均勻后澆注平板。
3、如下圖在平板上標(biāo)注樣品位置,放置牛津杯,在牛津杯中加入270ul 樣品。每個(gè)配比兩個(gè)板。32℃下培養(yǎng)22h 觀察記錄。

4、設(shè)置空白對(duì)照板。
六、實(shí)驗(yàn)情況
1:250

1:500

1:1000

1:2000

環(huán)境中提取的菌


七、觀察記錄分析
1、1:250 組大豆酪蛋白板
KV300,抑菌圈完整透明整潔,大小約3cm,板1 板2 基本一致。
KV360,抑菌圈基本完整,半透明,邊緣與KV500 交叉,圈上有單菌落和絨狀物,大小約2.5-3cm,板1 、板2 基本一致。
KV500,抑菌圈基本完整,半透明,邊緣與KV360交叉,圈上有單菌落和絨狀物,大小約5cm板1、板2 基本一致。
PC300,抑菌圈完整透明整潔,大小約3cm,板1 板2 基本一致。
KV360,抑菌圈基本完整,半透明,邊緣與KV500 交叉,圈上有單菌落和絨狀物,大小約2.5-3cm,板1 、板2 基本一致。
KV500,抑菌圈基本完整,半透明,邊緣與KV360交叉,圈上有單菌落和絨狀物,大小約5cm板1、板2 基本一致。
PC300,抑菌圈完整透明整潔,大小約3cm,板1 板2 基本一致。
分析,目測(cè)板上微生物主要為細(xì)菌及少量曲霉,從抑菌圈大小看,KV500 效果佳,另外3 種差不多。從抑菌圈的干凈度看,KV300 和PC300 效果佳,目測(cè)圈內(nèi)無微生物,KV500 邊緣部分有微生物,KV360 圈內(nèi)有微生物,分析可能為不能抑制接種液中所有種類的微生物或者是抑制效果弱。
2、1:500 組大豆酪蛋白板
KV300,大小約2.8cm,其他情況同1:250 組。
KV360,大小約2.7cm,其他情況同1:250 組。
KV500,大小約4.2cm,其他情況同1:250 組。
PC300,大小約2.7cm,其他情況同1:250 組。
KV360,大小約2.7cm,其他情況同1:250 組。
KV500,大小約4.2cm,其他情況同1:250 組。
PC300,大小約2.7cm,其他情況同1:250 組。
3、1:1000 組大豆酪蛋白板
KV300,大小約2.5cm,其他情況同1:250 組。
KV360,大小2.1-2.3cm,其他情況同1:250 組。
KV500,大小約4cm,其他情況同1:250 組。
PC300,大小約2.5cm,其他情況同1:250 組。
KV360,大小2.1-2.3cm,其他情況同1:250 組。
KV500,大小約4cm,其他情況同1:250 組。
PC300,大小約2.5cm,其他情況同1:250 組。
4、1:2000 組大豆酪蛋白板
KV300,大小約2cm,其他情況同1:250 組。
KV360,大小約2cm,其他情況同1:250 組。
KV500,大小約3.5cm,其他情況同1:250 組。
PC300,大小約2cm,其他情況同1:250 組。
KV360,大小約2cm,其他情況同1:250 組。
KV500,大小約3.5cm,其他情況同1:250 組。
PC300,大小約2cm,其他情況同1:250 組。
5、1:250 組孟加拉紅板
KV360 無抑菌圈,KV300、KV500、PC300 抑菌圈連成片,板1 板2 基本一致。
6、1:500 組孟加拉紅板
KV360 無抑菌圈,KV300、KV500、PC300 抑菌圈連成片,目測(cè)大小KV300>KV500>PC300。板1、板2基本一致。
7、1:1000 組孟加拉紅板
KV360 無抑菌圈,KV300、KV500、PC300 抑菌圈連成片,目測(cè)大小差不多,PC300 小一些。板1、板2基本一致。
8、1:2000 組孟加拉紅板
KV360 無抑菌圈,KV300、KV500、PC300 抑菌圈連成片,KV300 和KV500 約2.5cm,PC300 小一些,邊上有絨狀物。板1 板2 基本一致。
八、小結(jié)
1、隨著稀釋倍數(shù)的逐步放大,樣品的抑菌效果逐步減弱。
2、大豆酪蛋白板,KV500 的圈大,邊緣會(huì)有些菌帶,說明邊緣部分的抑制效果較弱。KV300 和PC300圈沒KV500 大,圈內(nèi)干凈無菌落,說明對(duì)接種液內(nèi)的細(xì)菌都有較好的抑制效果。
3、KV360 對(duì)接種液中的曲霉類真菌無效果,KV300、PC300、KV500 效果差不多,PC300 的圈邊緣有些菌帶,效果弱一些。如配方體系必須用KV360,可與KV500或KV300復(fù)配使用,具體以用戶試驗(yàn)結(jié)果為準(zhǔn)。
2、大豆酪蛋白板,KV500 的圈大,邊緣會(huì)有些菌帶,說明邊緣部分的抑制效果較弱。KV300 和PC300圈沒KV500 大,圈內(nèi)干凈無菌落,說明對(duì)接種液內(nèi)的細(xì)菌都有較好的抑制效果。
3、KV360 對(duì)接種液中的曲霉類真菌無效果,KV300、PC300、KV500 效果差不多,PC300 的圈邊緣有些菌帶,效果弱一些。如配方體系必須用KV360,可與KV500或KV300復(fù)配使用,具體以用戶試驗(yàn)結(jié)果為準(zhǔn)。
隨著體外診斷技術(shù)的不斷創(chuàng)新,我國(guó)體外診斷試劑行業(yè)獲得快速發(fā)展,相關(guān)產(chǎn)品更是日新月異,不斷升級(jí)。在配制各種液體試劑或液體制劑中。特別是體外診斷試劑的研發(fā)、生產(chǎn)過程中,除準(zhǔn)確性和重復(fù)性外,同樣需保證產(chǎn)品的良好適用性和品質(zhì),且低毒高效、通用性廣、生態(tài)環(huán)境友好。
在體外診斷試劑行業(yè)中,殺菌抑菌等防腐劑的選擇至關(guān)重要,決定體外診斷試劑質(zhì)量的好壞。西寶生物十多年作為生物試劑原料專業(yè)服務(wù)商,一直致力于提供長(zhǎng)效、廣譜、高效、低毒、環(huán)保的防腐劑。自主開發(fā)的新型無毒環(huán)保體外診斷試劑專用防腐劑KroVin500 (KV500),可替代傳統(tǒng)的NaN3、硫柳汞等對(duì)人體及環(huán)境毒害大的防腐劑產(chǎn)品。詳情咨詢400-021-8158或訪問我司網(wǎng)站www.0571x.cn.
KroVin?500防腐劑(活性成份為α-巰基-N-氧化物水溶液)
作用機(jī)理
KroVin500生物防腐劑作為離子載體,可穿過細(xì)菌的細(xì)胞膜,將質(zhì)子運(yùn)入細(xì)胞,攜帶鉀離子離去,經(jīng)過反復(fù)穿梭破壞了細(xì)胞膜兩邊的離子梯度,使細(xì)胞膜不能運(yùn)輸養(yǎng)分而導(dǎo)致細(xì)胞死亡。
在此過程中,KroVin500自身并沒有消耗,故能持續(xù)發(fā)揮作用。
產(chǎn)品特點(diǎn)
- 防霉抗菌效果極佳:本品對(duì)黑曲霉、黃曲霉、變色曲霉、桔青霉、宛氏擬青霉、綠色木霉、球毛殼霉、臘葉芽枝霉等顯示出極佳霉菌防霉抗菌效果。
- 細(xì)菌抗菌效果優(yōu)秀:本品對(duì)大腸桿菌、金黃色葡萄球菌、桔草芽胞桿菌、巨大芽孢桿菌、熒光假單胞桿菌等細(xì)菌均顯示出優(yōu)秀的抑殺效果。
- 酵母抗菌效果良好:本品對(duì)酒精酵母、啤酒酵母等多種酵母菌均顯示出良好的抑殺效果。
- 安全性高:對(duì)小鼠急性經(jīng)口LD50>1000mg/kg;對(duì)皮膚無刺激性;三致試驗(yàn)陰性。
- 溶劑相溶性:易溶于水,在pH5-11范圍內(nèi)都有效;特別適合在堿性和中性條件下穩(wěn)定,酸性條件下效果略有下降。
- 廣譜、長(zhǎng)效,替代傳統(tǒng)的防腐劑:NaN3、硫柳汞等對(duì)人體及環(huán)境毒害大的產(chǎn)品。
- 它與重金屬離子能發(fā)生螯合反應(yīng)(可中和重金屬離子對(duì)產(chǎn)品或配液體系干擾)。
質(zhì)量指標(biāo):
Active principle | 40.0%~41.0% |
Density | 1.10~1.3 g/ml |
pH | 9.0~11.0 |
Shape and properties | Light yellow liquid |
應(yīng)用領(lǐng)域
KroVin 500系列防腐劑pH耐受適用范圍廣,pH 5~11(最適PH6.5~10.5),化學(xué)穩(wěn)定性好,可與水及陰離子、陽離子、非離子等各種離子型乳化劑、表面活性劑以及血清、蛋白質(zhì)、酶等配伍。
適用比例:0.05~0.2%;具體根據(jù)樣本體系確定,必要時(shí)可提高濃度。也可與KroVin300、KroVin360混合使用,效果更好。
主要有以下應(yīng)用:
1)對(duì)照品、包被液、封閉液、穩(wěn)定液、稀釋液、緩沖液;
2)血?dú)夥治觥⒀蛟噭⑾♂屢旱龋?
3)校準(zhǔn)液(pH等);
4)清洗液和容器、管道、水槽等清洗和消殺抑菌;
5)體外診斷試劑盒和試劑配制。
6) 也可配制消毒劑、洗潔劑和廣譜抗真菌皮膚科用藥等產(chǎn)品。
1)對(duì)照品、包被液、封閉液、穩(wěn)定液、稀釋液、緩沖液;
2)血?dú)夥治觥⒀蛟噭⑾♂屢旱龋?
3)校準(zhǔn)液(pH等);
4)清洗液和容器、管道、水槽等清洗和消殺抑菌;
5)體外診斷試劑盒和試劑配制。
6) 也可配制消毒劑、洗潔劑和廣譜抗真菌皮膚科用藥等產(chǎn)品。
包裝儲(chǔ)存
本品包裝規(guī)格為25ml、100ml、500ml、5L。在正常室溫儲(chǔ)存情況下,可穩(wěn)定儲(chǔ)存二年。儲(chǔ)存期內(nèi),如發(fā)現(xiàn)沉淀物,使用前混合均勻,不影響其殺菌效果。
注意事項(xiàng)
1、本品雖然低毒、使用安全,但仍需避免接觸嘴巴、眼睛和皮膚。操作時(shí)請(qǐng)做好防護(hù)工作。
2、請(qǐng)于避光陰涼處貯存。
3、本品與一些氧化劑不相容,如過酸鹽、亞硫酸鹽等。對(duì)光、氧化劑和強(qiáng)還原劑不穩(wěn)定。非離子表面活性劑會(huì)微弱影響(可適當(dāng)加大用量),它與重金屬離子能發(fā)生螯合反應(yīng)(可中和重金屬離子對(duì)產(chǎn)品或配液體系干擾)。
4、使用時(shí)溫度不要超過45℃。
Seebio更多防腐劑系列應(yīng)用領(lǐng)域
應(yīng)用 產(chǎn)品系列 | PH適用范圍 | 免疫層析、膠體金 | 酶聯(lián)免疫、化學(xué)發(fā)光 | 生化 | 血?dú)夥治?血球 | 儀器設(shè)備管道清洗消毒 | ||
對(duì)照品 | 樣本 稀釋液 | 酶標(biāo) 稀釋液 | ||||||
KroVin 100 | ☆ | ☆ | ||||||
KroVin 200 | 3-9.5 | ☆ | ☆ | ☆ | ☆ | ☆ | ||
KroVin 300 | 2-9.5 | ☆ | ☆ | ☆ | ☆ | ☆ | ||
KroVin 360 | 3-8.5 | ☆ | ☆ | ☆ | ☆ | ☆ | ☆ | ☆ |
KroVin 500 | 5-11 | ☆ | ☆ | ☆ | ☆ | |||
KroVin 950 | 2-12 | ☆ | ☆ | ☆ | ☆ | ☆ | ||
KroVin?500殺抑菌效果測(cè)試與性能比較
一、實(shí)驗(yàn)原理
通過KroVin?500等系列工作濃度、接種到易染實(shí)驗(yàn)室及倉庫等環(huán)境試驗(yàn)菌的培養(yǎng)皿,在一定時(shí)間培養(yǎng)過程中,隨著各抑菌劑從原點(diǎn)向周圍的輻射,會(huì)有圓形區(qū)域無法長(zhǎng)出菌苔,從而顯示其抑菌作用。實(shí)驗(yàn)通過抑菌圈及直徑大小判斷其抑菌能力。
二、實(shí)驗(yàn)用品
85mm 培養(yǎng)皿、離心管、移液器、移液管、生物安全柜、生理鹽水、恒溫培養(yǎng)箱、無菌純水、接種環(huán)、涂棒、孟加拉紅瓊脂培養(yǎng)基、大豆胰蛋白培養(yǎng)基等。
三、菌種
取西寶公司實(shí)驗(yàn)室、生產(chǎn)車間、倉庫、過道的角落和設(shè)備處,用無菌棉球蘸取污物,接種到營(yíng)養(yǎng)肉湯瓊脂平板、孟加拉紅瓊脂平板、馬鈴薯葡萄糖瓊脂平板,32℃培養(yǎng)長(zhǎng)出菌落菌苔,挑取平板上易感代表性的菌落加入生理鹽水,制成混合菌接種液,接種液麥?zhǔn)蠞岫? 左右。
四、抑制劑
KroVin300(下圖簡(jiǎn)稱“KV300”,貨號(hào):ACN0037B,品牌:Seebio)
KroVin360(下圖簡(jiǎn)稱“KV360”,貨號(hào):ACN0917A,品牌:Seebio)
KroVin500(下圖簡(jiǎn)稱“KV500”,貨號(hào):ACN0046A,品牌:Seebio)
Proclin 300(下圖簡(jiǎn)稱“P*300”,品牌:進(jìn)口某Si*a品牌)
KroVin360(下圖簡(jiǎn)稱“KV360”,貨號(hào):ACN0917A,品牌:Seebio)
KroVin500(下圖簡(jiǎn)稱“KV500”,貨號(hào):ACN0046A,品牌:Seebio)
Proclin 300(下圖簡(jiǎn)稱“P*300”,品牌:進(jìn)口某Si*a品牌)
五、操作
1、將4 種抑制劑配制成1:250、1:500、1:1000、1:2000 的樣品存放2-8 度待用。配制大豆絡(luò)蛋白和孟加拉紅瓊脂培養(yǎng)基,各200ml,121℃滅菌15min,潔凈
2、生物安全柜內(nèi)冷卻至50℃左右,各加入3ml 接種液,搖晃均勻后澆注平板。
3、如下圖在平板上標(biāo)注樣品位置,放置牛津杯,在牛津杯中加入270ul 樣品。每個(gè)配比兩個(gè)板。32℃下培養(yǎng)22h 觀察記錄。

4、設(shè)置空白對(duì)照板。
六、實(shí)驗(yàn)情況
1:250

1:500

1:1000

1:2000

環(huán)境中提取的菌

七、觀察記錄分析
1、1:250 組大豆酪蛋白板
KV300,抑菌圈完整透明整潔,大小約3cm,板1 板2 基本一致。
KV360,抑菌圈基本完整,半透明,邊緣與KV500 交叉,圈上有單菌落和絨狀物,大小約2.5-3cm,板1 、板2 基本一致。
KV500,抑菌圈基本完整,半透明,邊緣與KV360交叉,圈上有單菌落和絨狀物,大小約5cm板1、板2 基本一致。
PC300,抑菌圈完整透明整潔,大小約3cm,板1 板2 基本一致。
KV360,抑菌圈基本完整,半透明,邊緣與KV500 交叉,圈上有單菌落和絨狀物,大小約2.5-3cm,板1 、板2 基本一致。
KV500,抑菌圈基本完整,半透明,邊緣與KV360交叉,圈上有單菌落和絨狀物,大小約5cm板1、板2 基本一致。
PC300,抑菌圈完整透明整潔,大小約3cm,板1 板2 基本一致。
分析,目測(cè)板上微生物主要為細(xì)菌及少量曲霉,從抑菌圈大小看,KV500效果佳,另外3 種差不多。從抑菌圈的干凈度看,KV300 和PC300 效果佳,目測(cè)圈內(nèi)無微生物,KV500 邊緣部分有微生物,KV360 圈內(nèi)有微生物,分析可能為不能抑制接種液中所有種類的微生物或者是抑制效果弱。
2、1:500 組大豆酪蛋白板
KV300,大小約2.8cm,其他情況同1:250 組。
KV360,大小約2.7cm,其他情況同1:250 組。
KV500,大小約4.2cm,其他情況同1:250 組。
PC300,大小約2.7cm,其他情況同1:250 組。
KV360,大小約2.7cm,其他情況同1:250 組。
KV500,大小約4.2cm,其他情況同1:250 組。
PC300,大小約2.7cm,其他情況同1:250 組。
3、1:1000 組大豆酪蛋白板
KV300,大小約2.5cm,其他情況同1:250 組。
KV360,大小2.1-2.3cm,其他情況同1:250 組。
KV500,大小約4cm,其他情況同1:250 組。
PC300,大小約2.5cm,其他情況同1:250 組。
KV360,大小2.1-2.3cm,其他情況同1:250 組。
KV500,大小約4cm,其他情況同1:250 組。
PC300,大小約2.5cm,其他情況同1:250 組。
4、1:2000 組大豆酪蛋白板
KV300,大小約2cm,其他情況同1:250 組。
KV360,大小約2cm,其他情況同1:250 組。
KV500,大小約3.5cm,其他情況同1:250 組。
PC300,大小約2cm,其他情況同1:250 組。
KV360,大小約2cm,其他情況同1:250 組。
KV500,大小約3.5cm,其他情況同1:250 組。
PC300,大小約2cm,其他情況同1:250 組。
5、1:250 組孟加拉紅板
KV360 無抑菌圈,KV300、KV500、PC300 抑菌圈連成片,板1 板2 基本一致。
6、1:500 組孟加拉紅板
KV360 無抑菌圈,KV300、KV500、PC300 抑菌圈連成片,目測(cè)大小KV300>KV500>PC300。板1、板2基本一致。
7、1:1000 組孟加拉紅板
KV360 無抑菌圈,KV300、KV500、PC300 抑菌圈連成片,目測(cè)大小差不多,PC300 小一些。板1、板2基本一致。
8、1:2000 組孟加拉紅板
KV360 無抑菌圈,KV300、KV500、PC300 抑菌圈連成片,KV300 和KV500 約2.5cm,PC300 小一些,邊上有絨狀物。板1 板2 基本一致。
八、小結(jié)
1、隨著稀釋倍數(shù)的逐步放大,樣品的抑菌效果逐步減弱。
2、大豆酪蛋白板,KV500 的圈大,邊緣會(huì)有些菌帶,說明邊緣部分的抑制效果較弱。KV300 和PC300圈沒KV500 大,圈內(nèi)干凈無菌落,說明對(duì)接種液內(nèi)的細(xì)菌都有較好的抑制效果。
3、KV360 對(duì)接種液中的曲霉類真菌無效果,KV300、PC300、KV500 效果差不多,PC300 的圈邊緣有些菌帶,效果弱一些。如配方體系必須用KV360,可與KV500或KV300復(fù)配使用,具體以用戶試驗(yàn)結(jié)果為準(zhǔn)。
2、大豆酪蛋白板,KV500 的圈大,邊緣會(huì)有些菌帶,說明邊緣部分的抑制效果較弱。KV300 和PC300圈沒KV500 大,圈內(nèi)干凈無菌落,說明對(duì)接種液內(nèi)的細(xì)菌都有較好的抑制效果。
3、KV360 對(duì)接種液中的曲霉類真菌無效果,KV300、PC300、KV500 效果差不多,PC300 的圈邊緣有些菌帶,效果弱一些。如配方體系必須用KV360,可與KV500或KV300復(fù)配使用,具體以用戶試驗(yàn)結(jié)果為準(zhǔn)。


